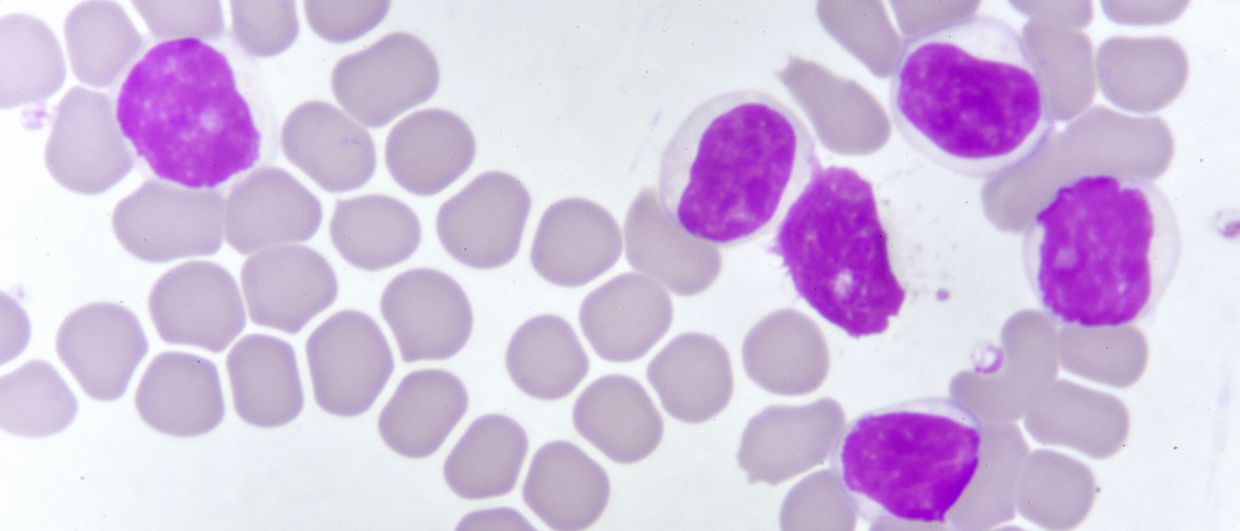
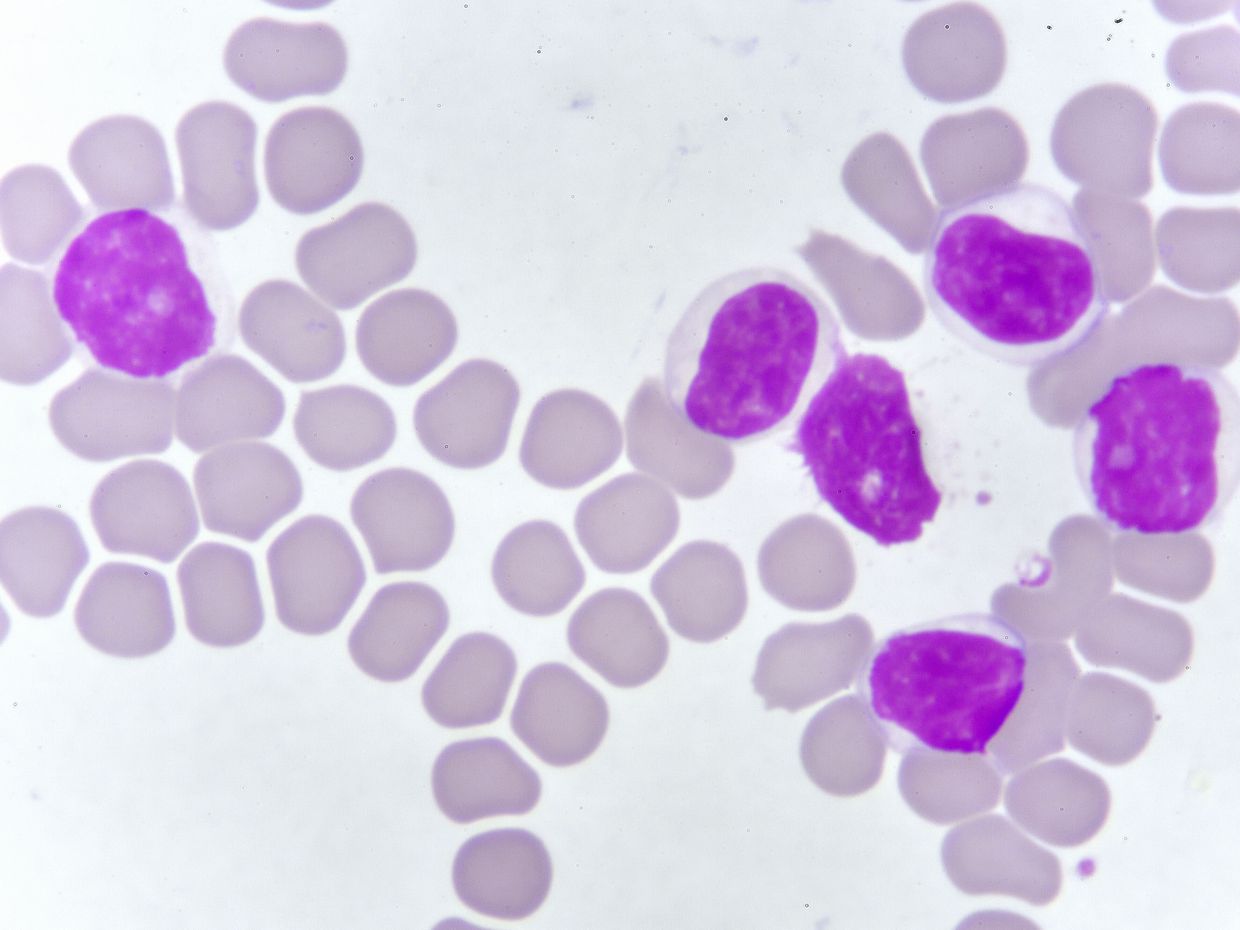

Informationen zum Kurs
Wissenschaftliche Leitung
Dr. med. Michael Gregor
Luzerner Kantonsspital
Redaktion
Dr. Therese Schwender
Chefredaktion
Dr. Nicole Leitner
Zielgruppe
Hämatologinnen und Hämatologen in Klinik und Praxis
Lehrziel
Nach der Lektüre dieses CME-Literaturstudiums wissen Sie, welche diagnostischen Kriterien für eine chronische lymphatische Leukämie (CLL) erfüllt sein müssen, welche Patienten behandlungsbedürftig sind, welche Optionen Ihnen für eine Erstlinientherapie sowie in der Rezidivsituation zur Verfügung stehen und nach welchen Kriterien die Wahl getroffen werden sollte.
Credits
Für die erfolgreich abgeschlossene Fortbildung – mind. 60% der Multiple-Choice-Fragen im Anschluss an das e-Learning richtig – vergibt die Schweizerische Gesellschaft für Hämatologie (SGH-SSH) im Rahmen der nachzuweisenden Kernfortbildung 2 Credits.
Fachbereich
Hämatologie
Organisation
Universimed Cross Media Content GmbH
Sponsoring
Die Realisierung dieser Fortbildung wurde von den Firmen Janssen-Cilag AG und Vifor AG finanziell unterstützt ohne Einflussnahme auf die Lehrinhalte.
Kosten
Dieser Kurs wird Ihnen kostenlos zur Verfügung gestellt.
Interessenskonflikt
keiner
Bitte beachten Sie, dass Sie den Test nur einmal durchführen können!